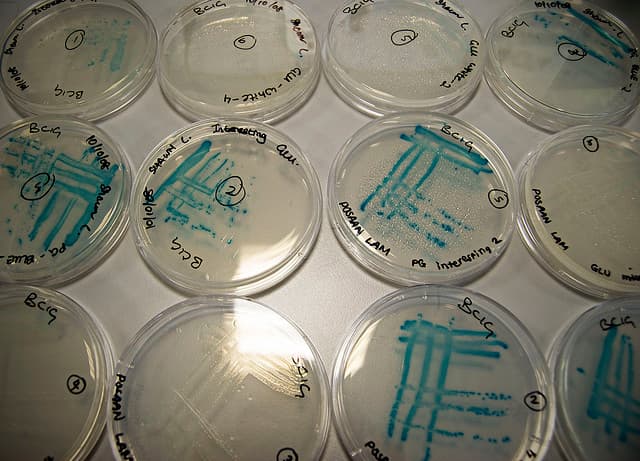
E Coli Kills Child in Virginia

60 People Poisoned in Denver Homeless Shelter
In what has been called the largest U.S. homeless shelter food poisoning outbreak in 10 years, people who ate at a Denve...
We use cookies to enhance your browsing experience, serve personalized content, and analyze our traffic. By clicking "Accept All", you consent to our use of cookies.
16 articles

In what has been called the largest U.S. homeless shelter food poisoning outbreak in 10 years, people who ate at a Denve...


Two high profile cases of food poisoning have appeared in the press during the last couple of days. 1) The Fat Du...

Tyrese had to hightail it to the hospital after eating some bad seafood last night. The "Sweet Lady" singer po...


Two more deaths and 300 new reported cases brings the gruesome e coli death toll to 26--25 in Germany and one in Sweden....

The e coli outbreak in Germany will, tragically, likely prove to be the largest in history. And just last weekend, a chi...

Lab results confirm a particularly deadly strain of e coli was present in the system of a child who died last weekend in...

The European e coli outbreak has now claimed 17 lives. There are wide reports of kidney failure in those infected. More ...

About 300 kids from 5 public schools in Guam became sick with food poisoning from cafeteria food. The schools are all ...

The Centers for Disease Control and Prevention has been saying for 11 years that people over 50 should heat up all deli ...

Mercedes Zambrano and her family were like the "Partridge Family" of the South American gatherings at the Kensington...

On the heels of a recent report from the University of Florida that discovered food poisonings cost the United States mo...

Monday evening, California-based Taylor Farms Pacific joined the grape tomato recall from earlier this week. Grower ...

We've all had food poisoning. It's really awful. And a recent study from the University of Florida revealed that the e...
Food poisoning isn't just a solid excuse to call in sick to the office. Food-borne illness not only kills, but takes a...